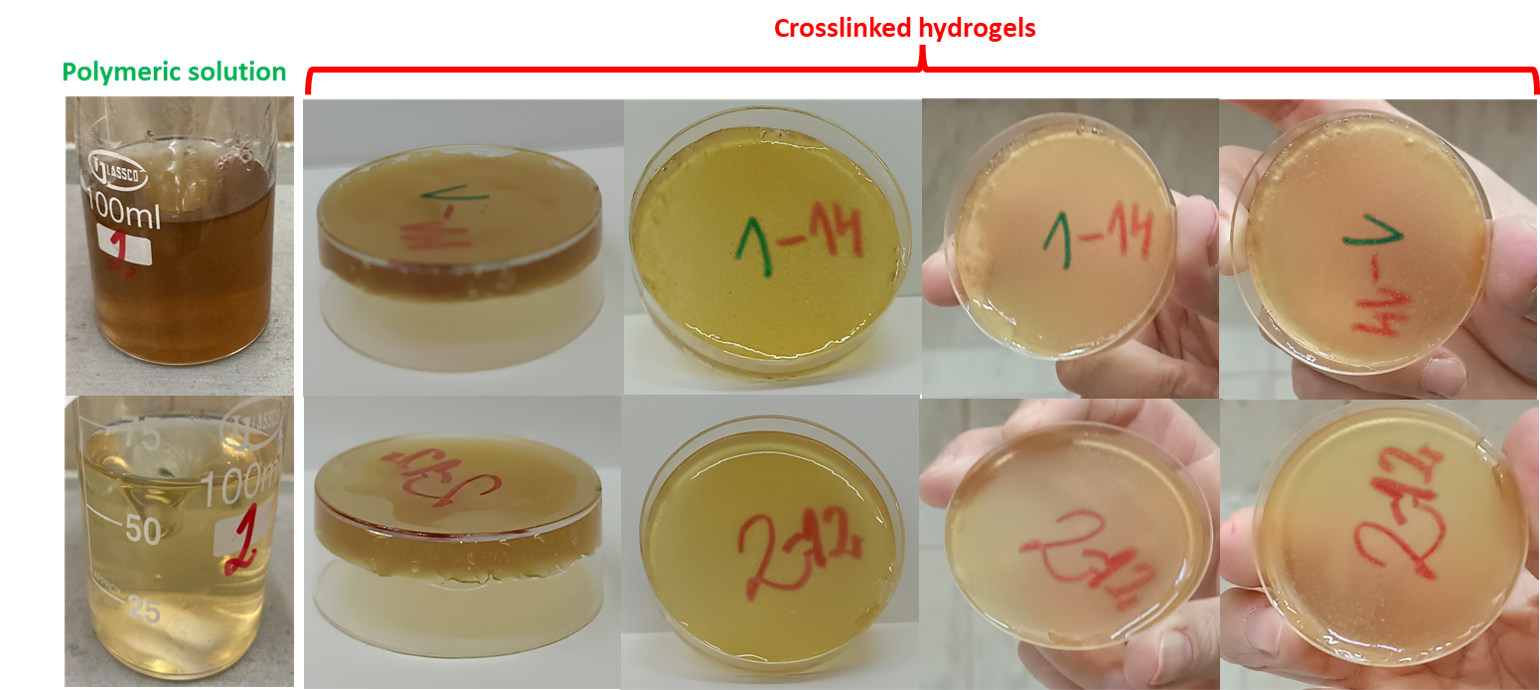
Figure 2

Results
STAGE 1 – 2025
During the reporting period, the project activities focused on optimizing the formulation of the biomimetic hydrogel based on gelatin, dextran, and standardized Aloe vera extract, as well as on establishing the specific parameters required for crosslinking and sterilization via accelerated electron-beam irradiation (6 MeV, ALID-7).
Act. 1.1 – Synthesis and Optimization of the Biomimetic Hydrogel Formulation
The main objective of Activity 1.1 was to select suitable polymer compositions and identify irradiation conditions that ensure structurally stable, homogeneous, and reproducible hydrogels. The characteristics of the electron beam, dose distribution within the material, and the minimum/maximum absorbed doses required for optimal crosslinking were thoroughly assessed. B3 radiochromic film dosimetry confirmed the uniformity of irradiation (Dmax/Dmin = 1.32), remaining within the limits specified by ISO 11137.
Based on the selected raw materials (gelatin Type B 75/225 Bloom, dextran 70/100 kDa, standardized Aloe vera extract, glycerol, and tannic acid), two main series of hydrogels were formulated and evaluated: (i) compositions without crosslinking agents and (ii) compositions enhanced through the incorporation of tannic acid as a natural crosslinker and glycerol as a plasticizer. The initial formulations enabled the identification of the compositional limits of the gelatin–dextran network, strongly influenced by the irradiation dose and the presence of standardized Aloe vera extract. Gel fraction and swelling degree measurements revealed clear differences between formulations, highlighting the need for further optimisation by introducing a crosslinking agent.

In the second stage, the improved formulations containing tannic acid (coded TA-AV1 and TA-AV2) led to stable polymer solutions with controlled pH values (7.3–7.7). Upon irradiation at doses between 13–27 kGy, these formulations produced homogeneous and structurally stable hydrogels that meet the experimental requirements for biomedical applicability.
Act. 1.2 – Determination of the Optimal Concentrations of Standardized Aloe Vera Extract with Pro-Regenerative Potential
Activity 1.2 focused on determining the optimal concentration of Aloe vera extract with pro-regenerative effects. In vitro studies on HaCaT and L929 cell lines demonstrated favorable biocompatibility and cell-proliferation profiles. MTT assays, phase-contrast morphological analysis, and LDH determinations indicated an optimal concentration range of 80–250 µg/mL. Within this interval, the extract enhanced cellular proliferation without inducing cytotoxicity. The results were consistent across both cell lines, supporting the potential of the extract to promote tissue regeneration.

Overall, the implementation period led to the establishment of the key parameters for hydrogel synthesis and irradiation, the development of optimized formulations, and the identification of effective concentrations of standardized extract for pro-regenerative applications. These results provide the technical foundation for subsequent stages of functional validation and integration into an advanced hydrogel-based wound dressing.
Act. 1.3 – Dissemination of Results
Deliverables Achieved
- 4 biomimetic hydrogel formulations: 3 containing standardized Aloe vera extract and 1 without Aloe vera extract;
- Establishment of the optimal concentration range of standardized Aloe vera extract with pro-regenerative potential: 80–250 µg/mL.
Result Indicators
- 1 ISI-indexed article classified as Q1.

